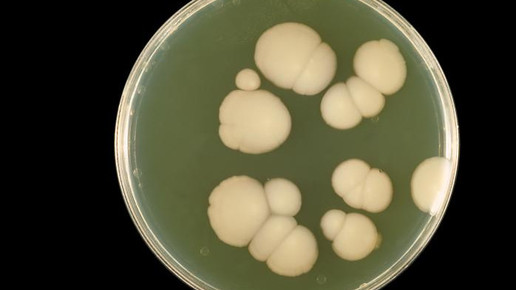
MRSA: Bedrohung durch multiresistente Pilze

MRSA: Bedrohung durch multiresistente Pilze
Die globale Gefahr durch multiresistente Keime (MRSA) ist im öffentlichen Bewusstsein zunehmend präsent. Seit einigen Jahren wird von allen Seiten versucht, der Ausbreitung der gefährlichen Mikroben Schranken zu setzen, sei es durch die Entwicklung neuer Arzneimittel, die Verringerung der Antibiotikagabe in der Tierzucht oder alternative Ansätze wie Bakteriophagen oder Blaues Plasma. Weitgehend unter dem Radar bewegt sich jedoch eine potenziell ebenso große Gefahr: multiresistente Pilze. So breitet sich seit einigen Jahren ein mysteriöser Pilz weltweit aus, dem kaum beizukommen ist: Candida auris. Dutzende Menschen hat er schon das Leben gekostet.
Bisher umgeben Candida auris mehr Fragen als Antworten: Niemand weiß, wo er herkommt, niemand kann sagen, wie weit er sich noch ausbreiten wird. Das erste mal beschrieben wurde der Pilz 2009 in Japan, wo Ärzte ihn im Gehörgang einer 70-jährigen Patientin fanden – „auris“ ist Lateinisch für Ohr. Der Hefepilz befällt jedoch weitaus mehr als nur das Hörorgan, unter anderem können auch Blutkreislauf, Harn- und Atemwege oder Wunden betroffen sein. Die gute Nachricht vorweg: Für die meisten gesunden Menschen ist der Pilz nicht lebensbedrohlich. Die Symptome sind hauptsächlich Fieber, Schmerzen und Fatigue.
Die schlechte Nachricht: Vor allem in Krankenhäusern und Pflegeeinrichtungen kann sich der Pilz rasend verbreiten – und ist kaum auszumerzen. Zahlen der US-Behörde für Seuchenschutz und Prävention (CDC) zufolge ist er in über 90 Prozent der bekannten Infektionen gegen mindestens ein gängiges Antimykotikum resistent, in 30 Prozent gegen mehrere. Noch beunruhigender: Laut CDC stirbt fast die Hälfte der Infizierten innerhalb von 90 Tagen. Dazu muss allerdings auch erwähnt werden, dass der „Killerpilz“, wie er in mehreren Medien bezeichnet wird, hauptsächlich Schwerkranke und Menschen mit geschwächtem Immunsystem befällt. Zur Zahl der weltweiten Todesopfer gibt es keine belastbaren Daten, aber sie dürften bereits in die Hunderte gehen, wenn man bedenkt, dass laut CDC allein in den USA bereits 617 Infektionen registriert wurden.
Denn nicht nur in den USA breitet sich der Pilz aus: Auch aus Großbritannien, Spanien, Indien, Pakistan, Südafrika, Japan, Venezuela und einer Reihe anderer Länder werden steigende Infektionszahlen vermeldet. In Deutschland gab es bisher nur Einzelfälle, in anderen Ländern dagegen bereits größere Ausbrüche mit dutzenden Infizierten. So waren Krankenhäuser in New York, London und Valencia betroffen, Altersheime in Chicago oder eine Neugeborenenstation in der venezolanischen Hauptstadt Caracas. Die US-Behörde CDC hat Candidas auris bereits auf die Liste der „akuten Bedrohungen“ gesetzt.
Allein im Royal Brompton Hospital nahe London gab es bei einem Ausbruch im Jahr 2015/16 rund 70 Betroffene, 50 von ihnen waren infiziert, 20 waren befallen, ohne dass der Pilz sich in ihrem Organismus eingenistet hatte – sie waren damit aber Träger und konnten andere Menschen anstecken. Das Krankenhaus schloss daraufhin seine Intensivstation für elf Tage, um sie komplett zu desinfizieren. Das stellte sich als schweres Unterfangen heraus.
Denn hat sich der Pilz einmal eingenistet, ist er extrem schwer wieder zu entfernen. Die New York Times hat mit der Ärztin Dr. Johanna Rhodes vom Imperial College London gesprochen – an sie hatte sich das Royal Brompton Hospital nach dem Ausbruch gewandt. Rhodes beschreibt ihr Vorgehen: Unter ihrer Aufsicht hatten Krankenhausmitarbeiter die Räume betroffener Patienten versiegelt und mit einem speziellen Gerät aerosolisiertes Wasserstoffperoxid versprüht. Eine Woche lang lief das Gerät, dann stellte Rhodes Petrischalen mit einer Nährlösung in den Räumen aus, auf denen sich überlebende Mikroben vermehren können. Nichts hatte überlebt – außer Candidas auris.
Damit machte das Mount Sinai Hospital in New York Erfahrungen, wo vergangenen Sommer ein älterer Patient einer Operation am Bauch unterzogen wurde und sich mit Candidas auris infizierte. Wenige Wochen später war er tot – im Gegensatz zu dem Pilz. Der hatte sich im gesamten Krankenzimmer ausgebreitet und war so gut wie nicht zu entfernen. Daraufhin untersuchte man das Zimmer, in dem der Patient lag.
„Alles wurde positiv getestet – die Wände, das Bett, die Türen, die Vorhänge, die Telefone, das Waschbecken, die Matratze, das Bettgestell, die Lüftungsschächte, die Jalousien, die Decke, einfach alles in dem Raum war positiv“, erinnert sich der Leiter des Krankenhauses. Am Ende mussten die Decke und der Boden des Zimmers herausgerissen werden, um den Pilzbefall zu stoppen.
Die Fälle aus den USA und Großbritannien geben eine Vorahnung, was auch deutsche Kliniken und Praxen erwarten könnte. Dabei mahnen Experten, jetzt schon Maßnahmen zu ergreifen, um der Ausbreitung von Candidas auris zu gebieten, bevor es zu spät ist. Denn die Mechanismen, die zur Multiresistenz des Hefepilzes führten, sind wahrscheinlich ähnlich denen, die zur zunehmenden Verbreitung von multiresistenten Bakterien führten.
Während für die der exzessive Gebrauch von Antibiotika in der Massentierhaltung verantwortlich gemacht wird, vertreten Wissenschaftler wie der Mikrobiologe Dr. Jaques Meis vom CWZ Nijmegen die Auffassung, dass der unverhältnismäßige Einsatz von Fungiziden in der Landwirtschaft zur Verbreitung des Pilzes geführt hat. Eine Lösung, wie man Patienten, die sich mit multiresistentem Candidas auris infiziert haben, behandeln kann, hat allerdings auch er noch nicht.

APOTHEKE ADHOC Debatte